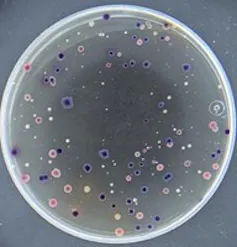
El cambio climático favorece el crecimiento de microorganismos patógenos que pueden llegar a nuestros grifos 1 Placa de Petri con manchas de colores.
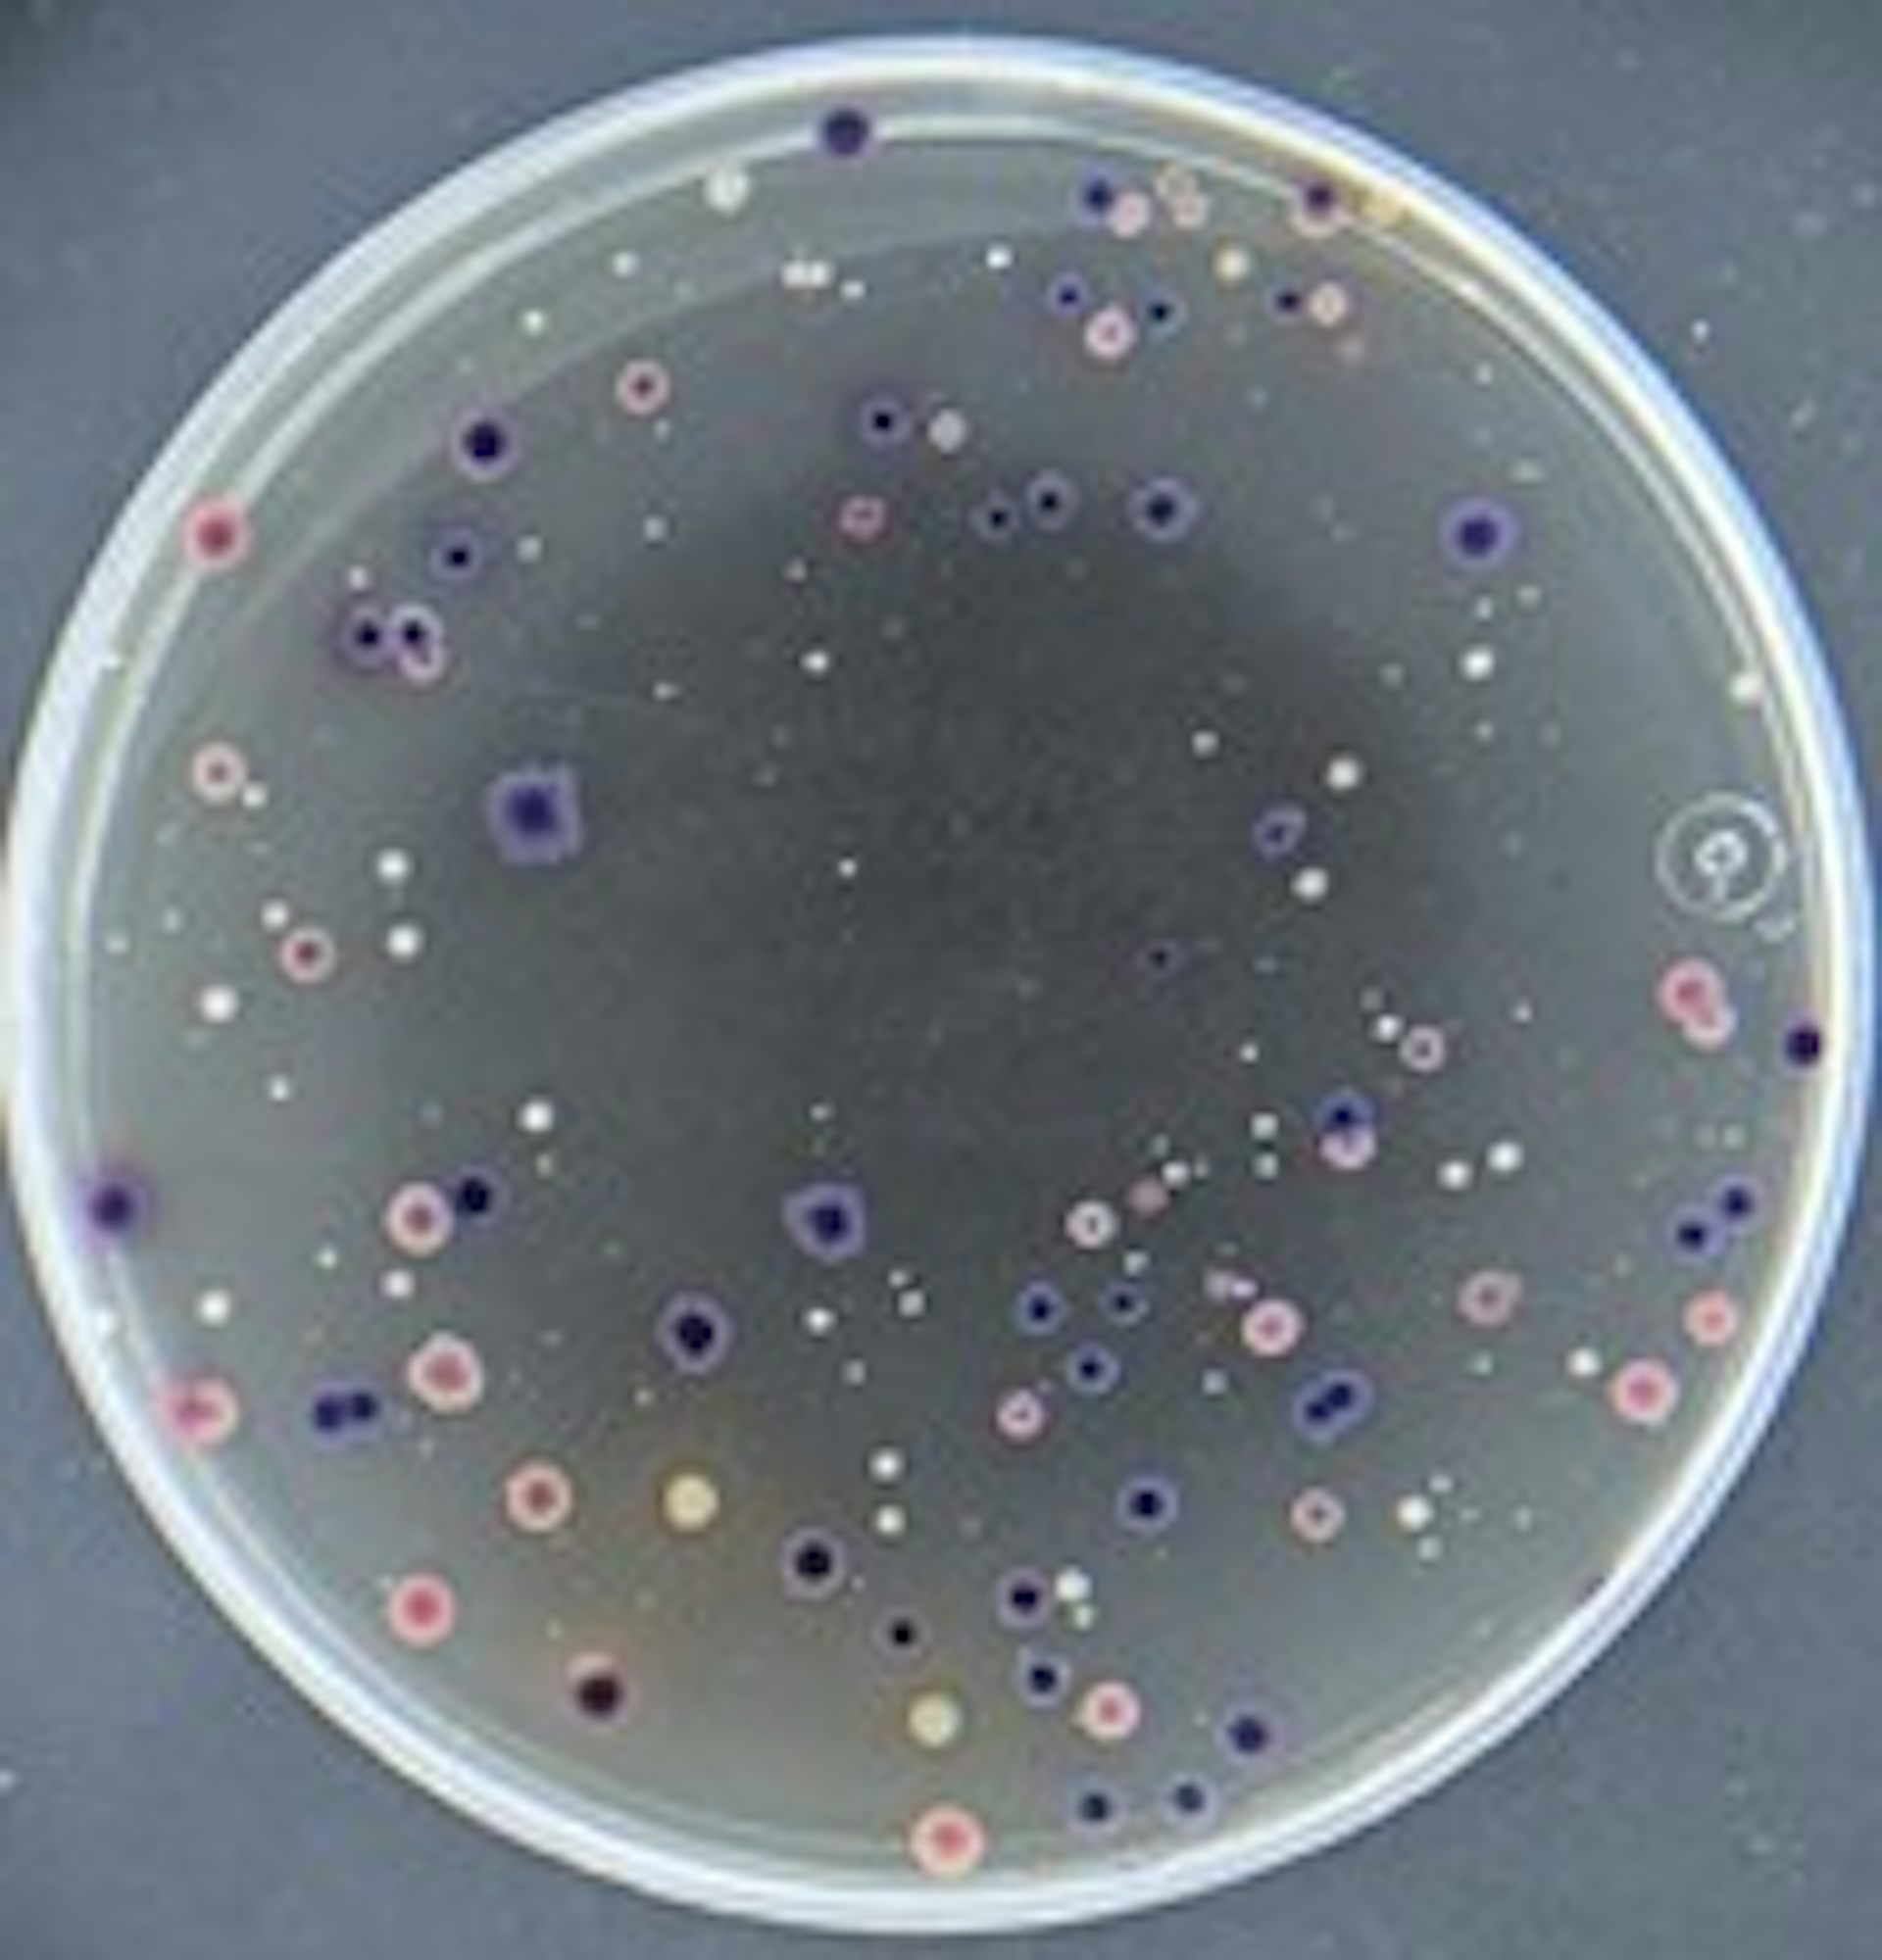
Placa de Petri con manchas de colores.
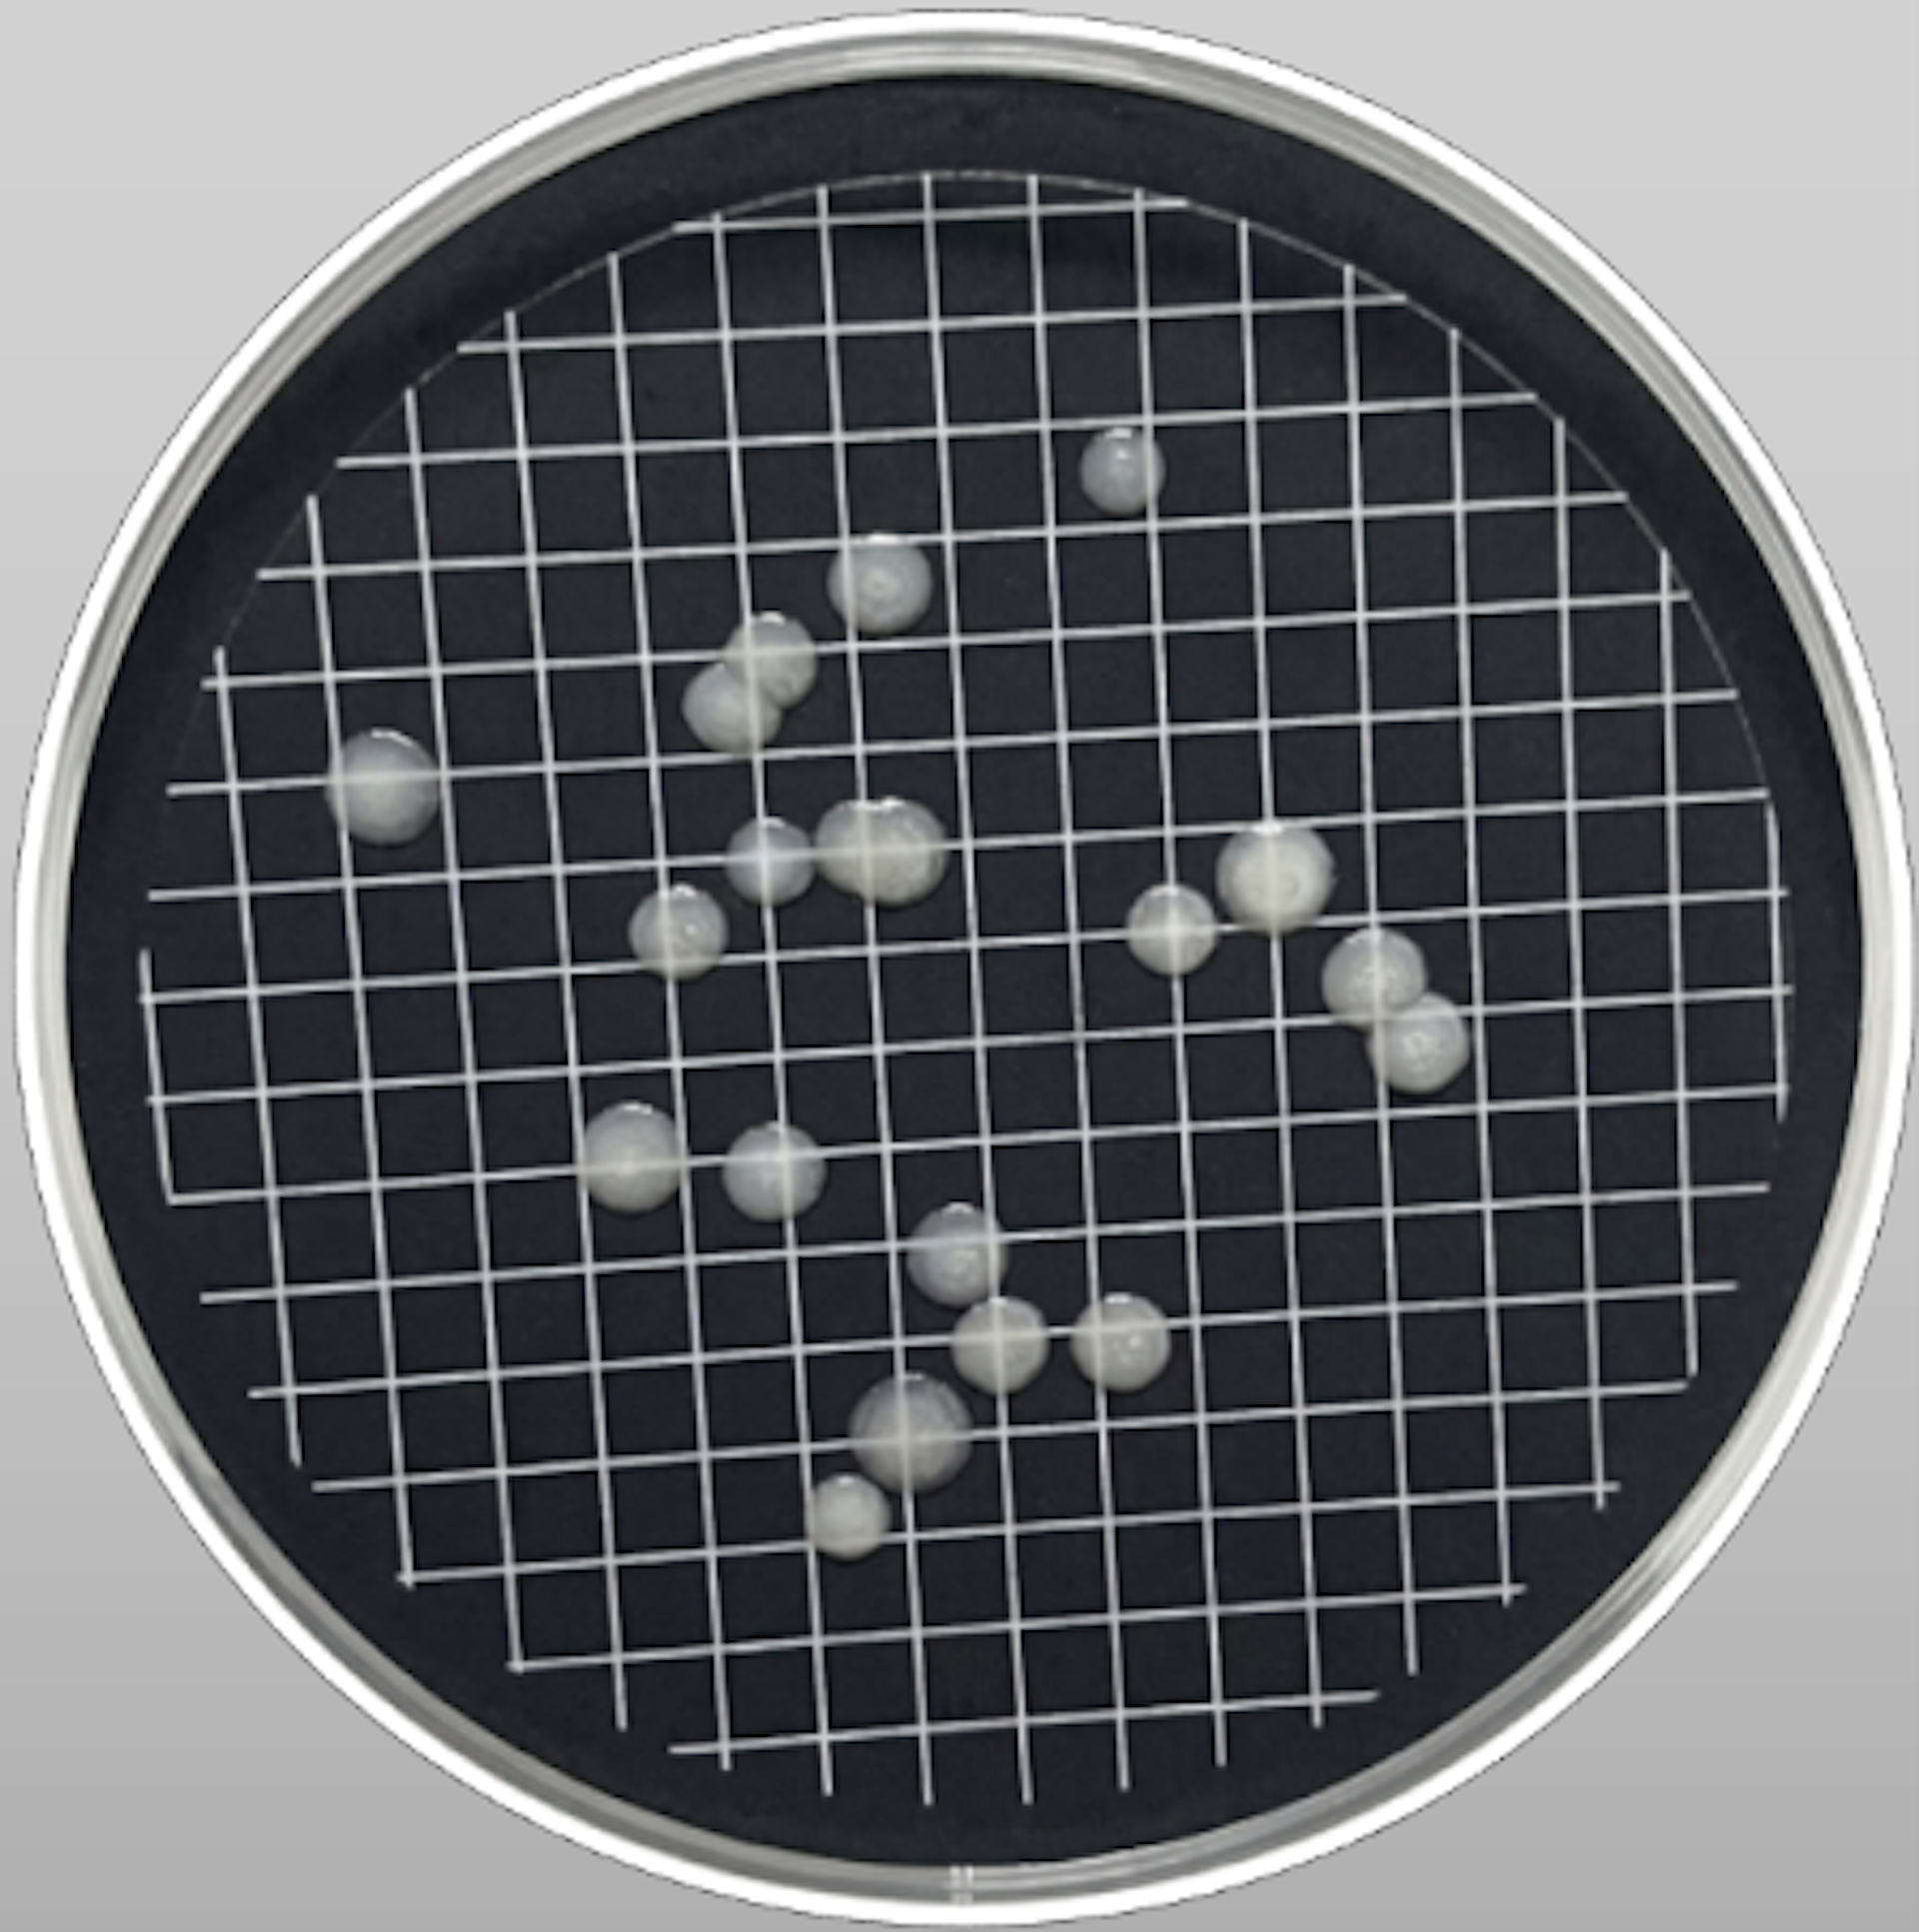
Placa de Petri con manchas blancas.
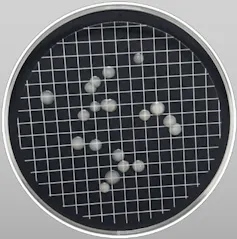
El cambio climático favorece el crecimiento de microorganismos patógenos que pueden llegar a nuestros grifos 2 Placa de Petri con manchas blancas.

Cada vez que abrimos el grifo de casa ni siquiera pensamos en si el agua que sale es segura. Si podemos verlo de forma transparente y no huele mal, parece suficiente. Sólo cuando iniciamos el viaje, dependiendo del destino, nos surgen dudas. De ello tienen la culpa algunos microorganismos patógenos, que pueden vivir y desarrollarse libremente en él. El problema es que no podemos verlos a simple vista, pero están ahí.
Después de muchos años de trabajar con estas diminutas criaturas, en mi último estudio he mostrado su impacto en la salud pública debido a su creciente prevalencia en el agua potable y su asociación con eventos climáticos extremos derivados del cambio climático.
Cuando se altera el equilibrio
Los microorganismos ocupan grandes extensiones de la Tierra debido a su facilidad de adaptación incluso a las condiciones ambientales más desfavorables. Su mera presencia en el agua potable no indica ningún peligro para la salud humana, incluso si están presentes en cantidades muy grandes.
El problema surge cuando se multiplican y propagan sin control y aparecen microorganismos patógenos que deterioran la calidad del agua, provocan olores y sabores desagradables y provocan enfermedades que pueden ser mortales.
Las bacterias, los virus y los protozoos son los microorganismos más comúnmente identificados en el agua potable, junto con las endotoxinas de algunas cianobacterias.
Escherichia coli, Salmonella, Vibrio, Legionella, helmintos (gusanos parásitos), virus que causan hepatitis, cianobacterias y una larga lista de otras son algunas de estas amenazas invisibles. Y es que pueden infectarse no sólo por ingestión, provocando enfermedades gastrointestinales, sino también a través de la piel o en forma de aerosoles que llegan a nuestros pulmones, como es el caso de la Legionella.
Asimismo, las toxinas producidas por cianobacterias o algas verdiazules son cada vez más frecuentes en las fuentes de abastecimiento de agua cuya temperatura supera los 20 ºC. Esto limita la disponibilidad de agua para consumo humano debido a su dificultad para ser eliminada en los sistemas de tratamiento.
Las algas verdiazules florecen en el lago Erie en Estados Unidos. Observatorio de la Tierra de la NASA. Landsat 5., CC BI-SA El desafío del cambio climático
El cambio climático es un verdadero desafío. La temperatura de la Tierra ha aumentado más de 1ºC en las últimas décadas y esta tendencia va en aumento, como reflejan los datos satelitales recogidos por la NOAA.
El aumento de temperatura favorece el crecimiento, la resistencia y la propagación de microorganismos. Pero no sólo eso, también es responsable de fenómenos meteorológicos extremos cada vez más frecuentes.
Las inundaciones hacen que grandes cantidades de agua circulen por el suelo, lixiviando nutrientes y contaminando las aguas superficiales. Por su parte, las sequías pueden provocar un deterioro de las condiciones sanitarias y una alta concentración de nutrientes que pueden llegar a las aguas subterráneas.
Todo esto proporciona a los microorganismos las condiciones ideales para su reproducción y expansión. Además, los desinfectantes pierden su eficacia ante aumentos de temperatura cada vez más extremos y persistentes.
Muchos brotes provocados por patógenos en el agua potable se producen tras periodos de inundaciones, como los identificados en el agua potable de la Comunidad Valenciana (España) tras el paso de grandes daños en octubre de 2024.
Y la lira también: Después de DÍAS: reacciones de salud pública
Microorganismos que se multiplican exponencialmente.

Crecimiento de colonias azules de Escherichia coli en la imagen de arriba y Legionella pneumophila en la imagen de abajo. Ambos casos provienen de muestras de agua potable. Ana Pérez Gimeno
Incluso en los países desarrollados, con controles y regulaciones estrictas, existen muchos puntos críticos, desde el suministro de agua hasta nuestro grifo. Esto hace que en situaciones climáticas extremas los microorganismos se multipliquen exponencialmente y tengan acceso a la red de suministro.
El Centro Europeo para la Prevención y el Control de Enfermedades (ECDC) vigila los fenómenos epidemiológicos que se producen periódicamente y busca el origen para suprimirlos. Las enfermedades del tracto gastrointestinal son comunes en verano, causadas por beber agua contaminada con las bacterias Escherichia coli, Salmonella, Vibrio o Campylobacter.
Si se hace un estudio sobre la evolución de los casos de legionelosis en la Unión Europea, se puede observar un evidente aumento en los últimos años, y los países más amenazados son Italia, Francia, Alemania y España. Estos países han experimentado veranos muy calurosos, entre 35 y 40 ºC, y altos niveles de humedad, lo que proporciona condiciones óptimas para el crecimiento y la propagación de la bacteria Legionella.

Evolución de los casos confirmados de legionelosis en Europa entre 2005 y 2023 Gráfico basado en datos proporcionados por ECDC, CC BI-SA Cómo afrontar el reto
La contaminación microbiológica es un desafío tanto en los países desarrollados como en los países en desarrollo, exacerbado por el calentamiento global. La crisis climática nos obliga a mirar el agua potable no sólo en términos de cantidad, sino también de calidad.
Por tanto, es fundamental entender que la salud de nuestras aguas comienza por minimizar los efectos del cambio climático. Se debe establecer una legislación global que rija los protocolos de monitoreo y control y se debe construir infraestructura resistente a eventos climáticos extremos.
Un ejemplo de la efectividad de este tipo de medidas es la drástica reducción de casos reportados de microorganismos en el agua potable en 2020, lo que se atribuye a estrictos controles y protocolos de higiene derivados de la epidemia mundial de Covid-19. Fue un hito en el desarrollo de procedimientos de análisis rápidos y precisos para identificar habitantes invisibles del agua para poder controlarlos y eliminarlos antes de que lleguen a nuestro grifo.
Lea también: Vigilancia del SARS-CoV-2 en aguas residuales: una herramienta de alerta rápida
Descubre más desde USA TODAY NEWS INDEPENDENT PRESS US
Suscríbete y recibe las últimas entradas en tu correo electrónico.


